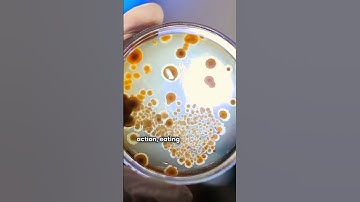
Dit beton REPAREERT zichzelf?! De toekomst van de bouw!

⬇ DOWNLOAD NOW
Kalau muncul iklan pop-up, tutup lalu klik tombol kembali
Download lagu Model Uncertainty in Reliability Analysis of FRP-to-Concrete Bond with Grooves secara gratis hanya untuk keperluan promosi. Dukung artis favorit kamu dengan membeli musik original di iTunes atau platform resmi lainnya.
 DAVID BIGAUD, Seismic structural reliability of FRP-strengthened RC frame
DAVID BIGAUD, Seismic structural reliability of FRP-strengthened RC frame
 API 579 Fitness For Service of FRP Educational Video 2 (FRP Damage Mechanisms)
API 579 Fitness For Service of FRP Educational Video 2 (FRP Damage Mechanisms)
Dit beton REPAREERT zichzelf?! De toekomst van de bouw!
Dit beton REPAREERT zichzelf?! De toekomst van de bouw!
 Informing safety and reducing uncertainty in ORE flexible structures
Informing safety and reducing uncertainty in ORE flexible structures
 E. MARTINELLI, Numerical Modelling Of Debonding And Fatigue Of Frp Strips Glued To Concrete
E. MARTINELLI, Numerical Modelling Of Debonding And Fatigue Of Frp Strips Glued To Concrete
 Convertible Bond Test Apparatus for EB FRP, NSM FRP, FRCM, and Allied Systems: Proof of Concept
Convertible Bond Test Apparatus for EB FRP, NSM FRP, FRCM, and Allied Systems: Proof of Concept
 NIST Engineering Laboratory (EL) Research on the Performance of Externally Bonded FRP
NIST Engineering Laboratory (EL) Research on the Performance of Externally Bonded FRP
 Tests programmes on bond-slip and bent capacity of GFRP rebars
Tests programmes on bond-slip and bent capacity of GFRP rebars